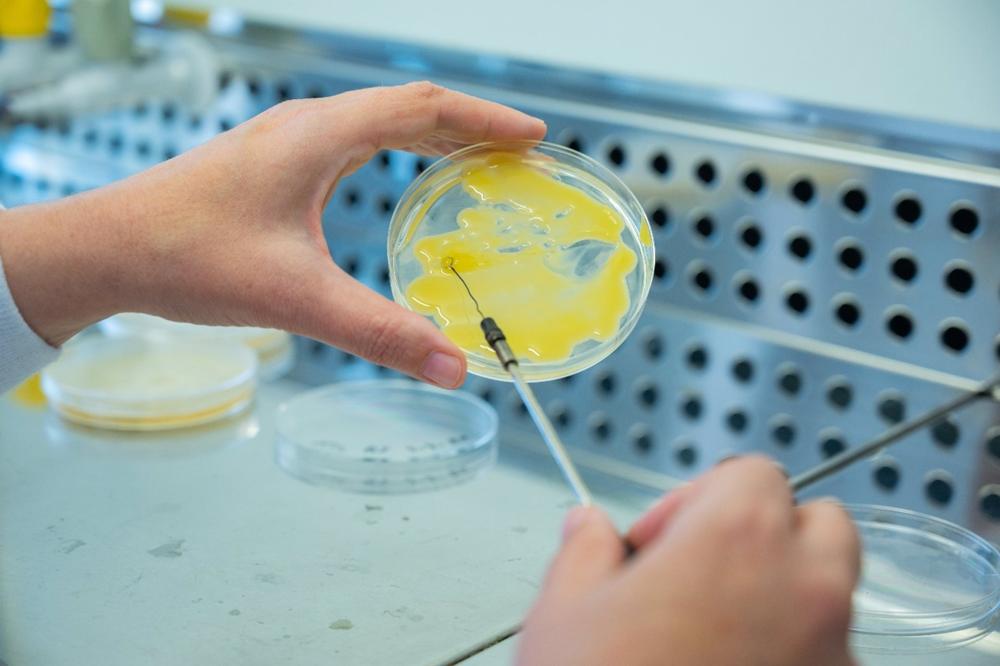
15

Quince investigadores del Consejo Superior de Investigaciones Científicas (CSIC) aparecen en la lista Highly Cited Researchers (HCR) 2022, elaborada por la plataforma Webofscience Group, de Clarivate Analytics, que reúne a los científicos más influyentes del mundo.
Esta clasificación, según ha informado el CSIC, identifica a los científicos que han producido múltiples estudios que se sitúan en el top 1% de citaciones en su campo y año de publicación, lo que demuestra «una elevada influencia entre la comunidad científica».
La metodología para determinar la selección de los investigadores más influyentes se basa en los datos y análisis desarrollados por los expertos en bibliometría del Institute for Scientific Information, del Web of Science Group.
En su sexta edición, el HCR incluye un total de 6.938 investigadores de 70 países, que destacan por sus excelentes contribuciones al conocimiento científico y por su influencia en sus respectivas áreas de conocimiento. Para ello, mide la publicación de artículos altamente citados entre los años 2002 y 2022.
Por países, la clasificación está liderada por Estados Unidos, que cuenta con el 38,3% del total de los científicos más influyentes (2.764); le siguen China y Reino Unido.
Los investigadores del CSIC que han sido incluidos en la lista son Miguel Bastos, Avelino Corma, Javier Francisco Corpas, Manuel Delgado-Baquerizo, Luis Enjuanes, Juan Carlos Espín, José Manuel Franco-Zorrilla, José M.Pardo, Juli García Pausas, Josep Peñuelas, Xavier Querol, Isidra Recio, Francisco Tomás-Barberán, Sergio Vicente Serrano y Montserrat Vilà.






